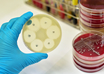

Low vitamin D levels may raise bowel cancer risk
Healthline/Medical News Today | Jun 19, 2018
'Surgery in a pill' could avoid post-meal sugar spike: Harvard Medical School
Harvard Medical School News | Jun 18, 2018
New position paper recommends treatment options for nightmare disorder in adults
American Academy of Sleep Medicine News | Jun 18, 2018
New compound identified to be as effective as FDA-approved drugs against life-threatening infections
Purdue University Research news | Jun 18, 2018
Type 2 diabetes linked to higher rate of Parkinson's
University College London News | Jun 17, 2018
Mayo Clinic discovery is first step toward new bacteria-based constipation treatment
Mayo Clinic | Jun 17, 2018
The curious case of a blind woman who sees motion
Healthline/Medical News Today | Jun 17, 2018
Tobacco aside, e-cigarette flavorings may harm blood vessels
American Heart Association News | Jun 17, 2018
How can disc desiccation be treated?
Healthline/Medical News Today | Jun 17, 2018
Infectious uveitis common among HIV-positive patients in South Africa
American Academy of Ophthalmology News | Jun 17, 2018